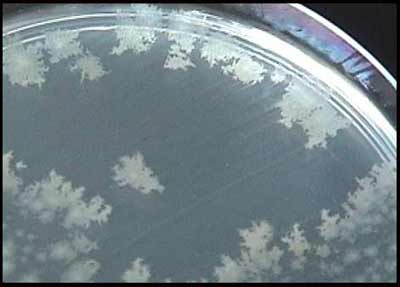

Espace Etudiant
Cours de Bactériologie Médicale
UNE BACTERIE D'ACTUALITE

1 - Introduction
Actuellement, Clostridium difficile, germe anaérobie strict de type bacille à Gram + est reconnu comme un entéropathogène majeur, à l'origine de colites pseudo-membraneuses ou de diarrhées post-antibiotiques. Cet agent est majoritairement impliqué dans les diarrhées nosocomiales de l'adulte.
2 - Historique
La première description de colite pseudo-membraneuse (CPM) date de 1893 (Finney) chez une jeune femme au décours d'une chirurgie digestive.
Trente ans plus tard, Hall et O'Toole décrivent la bactérie présente dans les selles de nouveau-nés asymptomatiques comme Bacillus difficilis en raison des difficultés rencontrées pour sa culture.
Ce n'est que dans les années 1970 que le rôle de C. difficile dans les CMP et diarrhées est reconnu. En effet, l'introduction de la clindamycine (famille des lincosamides) en thérapeutique entraîne une flambée d'observations de CPM. Puis Larson (Angleterre) et John Bartlett (USA)(Photo ci-jointe) démontrent l'existence d'une activité cytotoxique dans les selles de patients atteints de CPM post-antibiotiques. Enfin en 1984 sont caractérisées les toxines A (entérotoxine) et B (cytotoxine).
|
|
3 - Habitat
Le portage digestif asymptomatique de C. difficile est estimé à 3% dans la population adulte mais il peut atteindre 15 à 25% des sujets après un traitement antibiotique ou un séjour dans une unité à forte endémicité. En revanche, un taux de portage élevé est habituellement observé chez les jeunes enfants: 50-70% des enfants de moins de 2 ans sont colonisés. Ce germe est aussi commensal chez l'animal comme le porc.
4 - Epidémiologie
Cet agent est majoritairement impliqué dans les diarrhées nosocomiales de l'adulte. Plusieurs dizaines d'épidémies ont été décrites aux USA et en Europe. D'où une surveillance en milieu hospitalier.
http://infobits.chus.qc.ca/
http://www.hospvd.ch/
|
|
On peut être amené à confronter les souches isolées par différentes méthodes :
- phénotypique : sérogroupage;
- génotypiques : AP-PCR, PCR-ribotypage, électrophorèse en champ pulsé, toxinotypie (PCR-RFLP) analysant le polymorphisme des gènes codant pour les toxines A et B.
5 - Pouvoir pathogène
C. difficile est responsable de 15-25% des diarrhées post-antibiotiques. Les signes cliniques régressent dans 25% des cas après larrêt de lantibiotique responsable.
. Plus de 95% des CPM présentent les signes suivants: diarrhée, fièvre, douleurs abdominales, hyperleucocytose.
. Les complications sont graves: perforation, péritonite, mégacôlon toxique.
. Enfin les rechutes sont fréquentes (20%) et surviennent dans les 2 mois suivant lépisode.
. La quasi-totalité des antibiotiques ont été incriminés, en particulier ceux à large spectre ayant une activité vis-à-vis de la flore anaérobie.
|
|
Prévalence de C. difficile et de ses toxines dans les selles de différentes populations

http://www.angh.org/ndl_df_cag_diagnostic.htm
6 - Physiopathologie
- La prescription depuis plusieurs jours d'antibiotiques à large spectre (aminopénicillines, céphalosporines) ou à spectre étroit (clindamycine) entraine au sein de la flore digestive, l'émergence et la sélection de C. difficile qui va produire des toxines par la suite:

- Les 2 facteurs principaux de virulence sont la toxine A et la toxine B. Ce sont des exoprotéines de grande taille.
. La toxine A est nommée entérotoxine, car fortement entérotoxique dans le modèle de lanse ligaturée de lapin ; elle possède également une activité cytotoxique.
. La toxine B ou cytotoxine est mille fois plus puissante que la A. Ces toxines inactivent des protéines régulatrices du cytosquelette dactine (monoglycosylation des protéines Rho).
- Dautres facteurs (enzymes protéolytiques, expression de fimbriae et flagelles, adhésion, capsule) pourraient jouer un rôle. Certaines souches produisent une autre toxine (ADP-ribosyltransférase ou toxine binaire) qui pourrait participer au pouvoir pathogène. Les souches non toxinogènes sont considérées comme non virulentes.
http://www.uark.edu/campus-resources/mivey/ressum.html

7 - Diagnostic biologique
- Outre les aspects cliniques habituels, l'endoscopie associée ou non à la tomographie axiale permettra de visualiser certains aspects: Si la recto-sigmoïdoscopie avec visualisation des membranes est très spécifique, les pseudomembranes ne sont pas toujours présentes dans les colites.
- Le diagnostic bactériologique repose sur la recherche des toxines. En parallèle, la culture de C. difficile est recommandée. On reteindra qu'il s'agit d'un examen inhabituel demandé spécifiquement dans un contexte clinique particulier
1- Prélèvement
C. difficile est recherché à partir des selles liquides en évitant lécouvillonnage rectal. La recherche des toxines doit être effectuée à partir de selles ou de liquides intestinaux (examen endoscopique).
Si lexamen est différé, les échantillons doivent être conservés à 4°C. La conservation à température ambiante ou la congélation à 80°C diminuent notablement lactivité des cytotoxines.
|
|
2 - Mise en évidence des toxines
La grande majorité des souches produisent simultanément les toxines A et B. Leur mise en évidence directement à partir des selles est un excellent marqueur de la présence dune souche toxinogène de C. difficile. Des souches toxine A- toxine B+ sont maintenant décrites. Une étude japonaise rapporte une forte prévalence mais en France, leur fréquence reste faible (1,5 à 3%). Toutefois, ces souches (délétées dans la partie comportant lépitope reconnu par les Ac), ne sont pas dépistées par les tests immuno-enzymatiques ne détectant que la toxine A (http://microvet.arizona.edu/research/ClostridiumWeb/methods.html)
* La méthode de référence consiste à rechercher un effet cytopathogène (ECP) de la toxine B par culture cellulaire. Différentes lignées cellulaires sont utilisables: MRC5, Vero, CHO, HeP2.
. Sur MRC5 (cf ci-dessous), lECP correspond à une ballonisation des cellules (arrondissement du noyau et effondrement du cytoplasme avec apparition dune forte réfringence). Il est observé après dépôt dun filtrat de selles sur les cellules.
|
|
A gauche : culture cellulaire normale A droite: ballonisation des cellules

Cette méthode présente une excellente sensibilité (ordre du picogramme) mais se heurte à labsence de standardisation. Enfin, elle nécessite une infrastructure lourde, le délai de réponse est de plusieurs jours. Souvent seront préférés des test rapides.
* Tests immuno-enzymatiques
Des tests ELISA ou ceux unitaires immuno-enzymatiques ou immuno-chromatographiques ont été développés. Ils détectent soit la toxine A seule soit les toxines A et B au moyen danticorps monoclonaux ou polyclonaux. Les tests unitaires rapides permettent de rendre un résultat en moins de 30 minutes. La spécificité des méthodes ELISA est bonne (>95%) avec une sensibilité qui varie selon les études (60-90%).
Exemples d'un test rapide (Triage®) détectant la toxine A (+ à droite) et un antigène bactérien (glutamate déshydrogénase)(+ au milieu et à droite).

*Techniques de biologie moléculaire
|
|
La PCR pour détecter les toxines A et/ou B est encore dapplication limitée à cause de l'extraction des selles et de l'éventuelle présence d' inhibiteurs de la Taq polymérase. De nouveaux kits dextraction et le développement de la PCR en temps réel devraient rendre ces nouvelles approches intéressantes dans un avenir proche.
|
3- Culture et mise en évidence de la bactérie dans les selles
* Diagnostic rapide par recherche dantigène dans les selles
Il sagit de la glutamate déshydrogénase qui peut être mise en évidence par agglutination (test latex) ou par méthode immuno-enzymatique. La spécificité est bonne mais ces tests ne représentent que des méthodes de dépistage puisquils ne préjugent pas du caractère toxinogène de la souche.
* Isolement de C. difficile par culture
Lexamen microscopique des selles est peu informatif.
La culture est effectuée dans des conditions d'anaérobiose stricte (sachet individuel, jarre) sur milieux sélectifs comme le milieu TCCA (gélose cur cervelle + 5% de sang de cheval, 0,1% de taurocholate, 250 mg/l de cyclosérine et 10 mg/l de céfoxitine).
|
|
|
|
|
Les subcultures peuvent être effectuées sur gélose au sang ou milieu de Wilkins-Chalgren.
Après 48 h d'incubation en anaérobiose à 37°C, les colonies sont faciles à repérer, elles présentent les caractéristiques suivantes:
- colonies circulaires à bords irréguliers (3-5 mm), non hémolytiques;
- colonies présentant un aspect de verre fritté à la loupe binoculaire,
- odeur caractéristique de crottin de cheval (libération de crésol);
- colonies fluorescentes sous UV (mais dépend du milieu utilisé).
|
* L'identification peut être réalisée par utilisation de galeries biochimiques : rapid ID 32A, API 20A
) mais la plupart des caractères de cette bactérie sont négatifs. Elle ne produit pas d'indole, de lécithinase ou d'uréase à la différence de C. bifermentans et C. sordellii. L'identification définitive se fait par CLHP (détection d'acide isocaproïque).

* Méthodes de typage des souches: Différentes méthodes peuvent être utilisées :
- phénotypique : sérogroupe selon la technique de Michel Delmée (Bruxelles) ; - génotypiques : AP-PCR, PCR-ribotypage, électrophorèse en champ pulsé, toxinotypie (PCR-RFLP qui analyse le polymorphisme des gènes codant pour les toxines A et B).
8 - Sensibilité aux antibiotiques - traitement - prophylaxie
|
- Lantibiogramme ne présente qu'un intérêt taxonomique (résistance naturelle à certaines ß-lactamines dont la céfoxitine ou FOX).Cet antibiotique entre dans la composition du milieu TCCA.
Exemple d'antibiogramme:
FOX, céfoxitine; IPM, imipénème; AMX, amoxicilline; PIP, pipéracilline.
|
|
La résistance acquise à la clindamycine (CLI) est relativement fréquente. De rares souches de sensibilité diminuée au métronidazole ont été détectées en France mais sont à ce jour des souches de sérogroupe D (non toxinogène).
Sinon le traitement est simple:
1 - Arrêt de lantibiothérapie si possible
2 - Traitements spécifiques :
| Diarrhée simple ou colite modérée : |
Métronidazole (Flagyl®) 250 mg x 4/j ou 500 mg x 3 /j per os pendant 10 jours.
Lors dintolérance au Flagyl® ou de rechute : Vancomycine (Vancocin®) 125 mg x 4 /j per os pendant 10 jours |
|
En cas de CPM peu sévère
|
Vancomycine, 125 mg x 4 /j per os pendant 10 jours
|
En cas de CPM sévère (retentissement général ou terrain fragile) ou complication (perforation colique, dilatation colique aiguë)
|
Vancomycine : 500 mg mg x 4/j pendant 10-14 jours |
|
|
|
|
3 - Prévention des rechutes
Certaines études ont montré que lassociation dagents probiotiques ( Saccharomyces boulardii ou Lactobacillus GG) aux traitements antibiotiques usuels, diminuerait le taux de récurrence.
http://www.florastor.com/ReceptorSites.asp
4 - Prévention des infections nosocomiales
C. difficile est reconnu comme le principal agent de diarrhées nosocomiales chez ladulte. La prévention de la transmission repose sur lisolement technique et géographique des patients symptomatiques. Le lavage des mains avec un savon antiseptique (type chlorhexidine actif sur les spores) et port de gants sont des mesures essentielles. Léradication des réservoirs inertes est difficile du fait de la persistance des spores et impose une désinfection quotidienne.
http: //www.sante.gouv.fr/htm/pointsur/ nosoco/clostridium/annexe_ctinils.pdf
Ce cours a été préparé par le Docteur Dominique DECRÉ (Faculté de Médecine Saint-Antoine, Université PARIS VI)(Version 1, 29.07.04).
Pour en savoir plus :

|